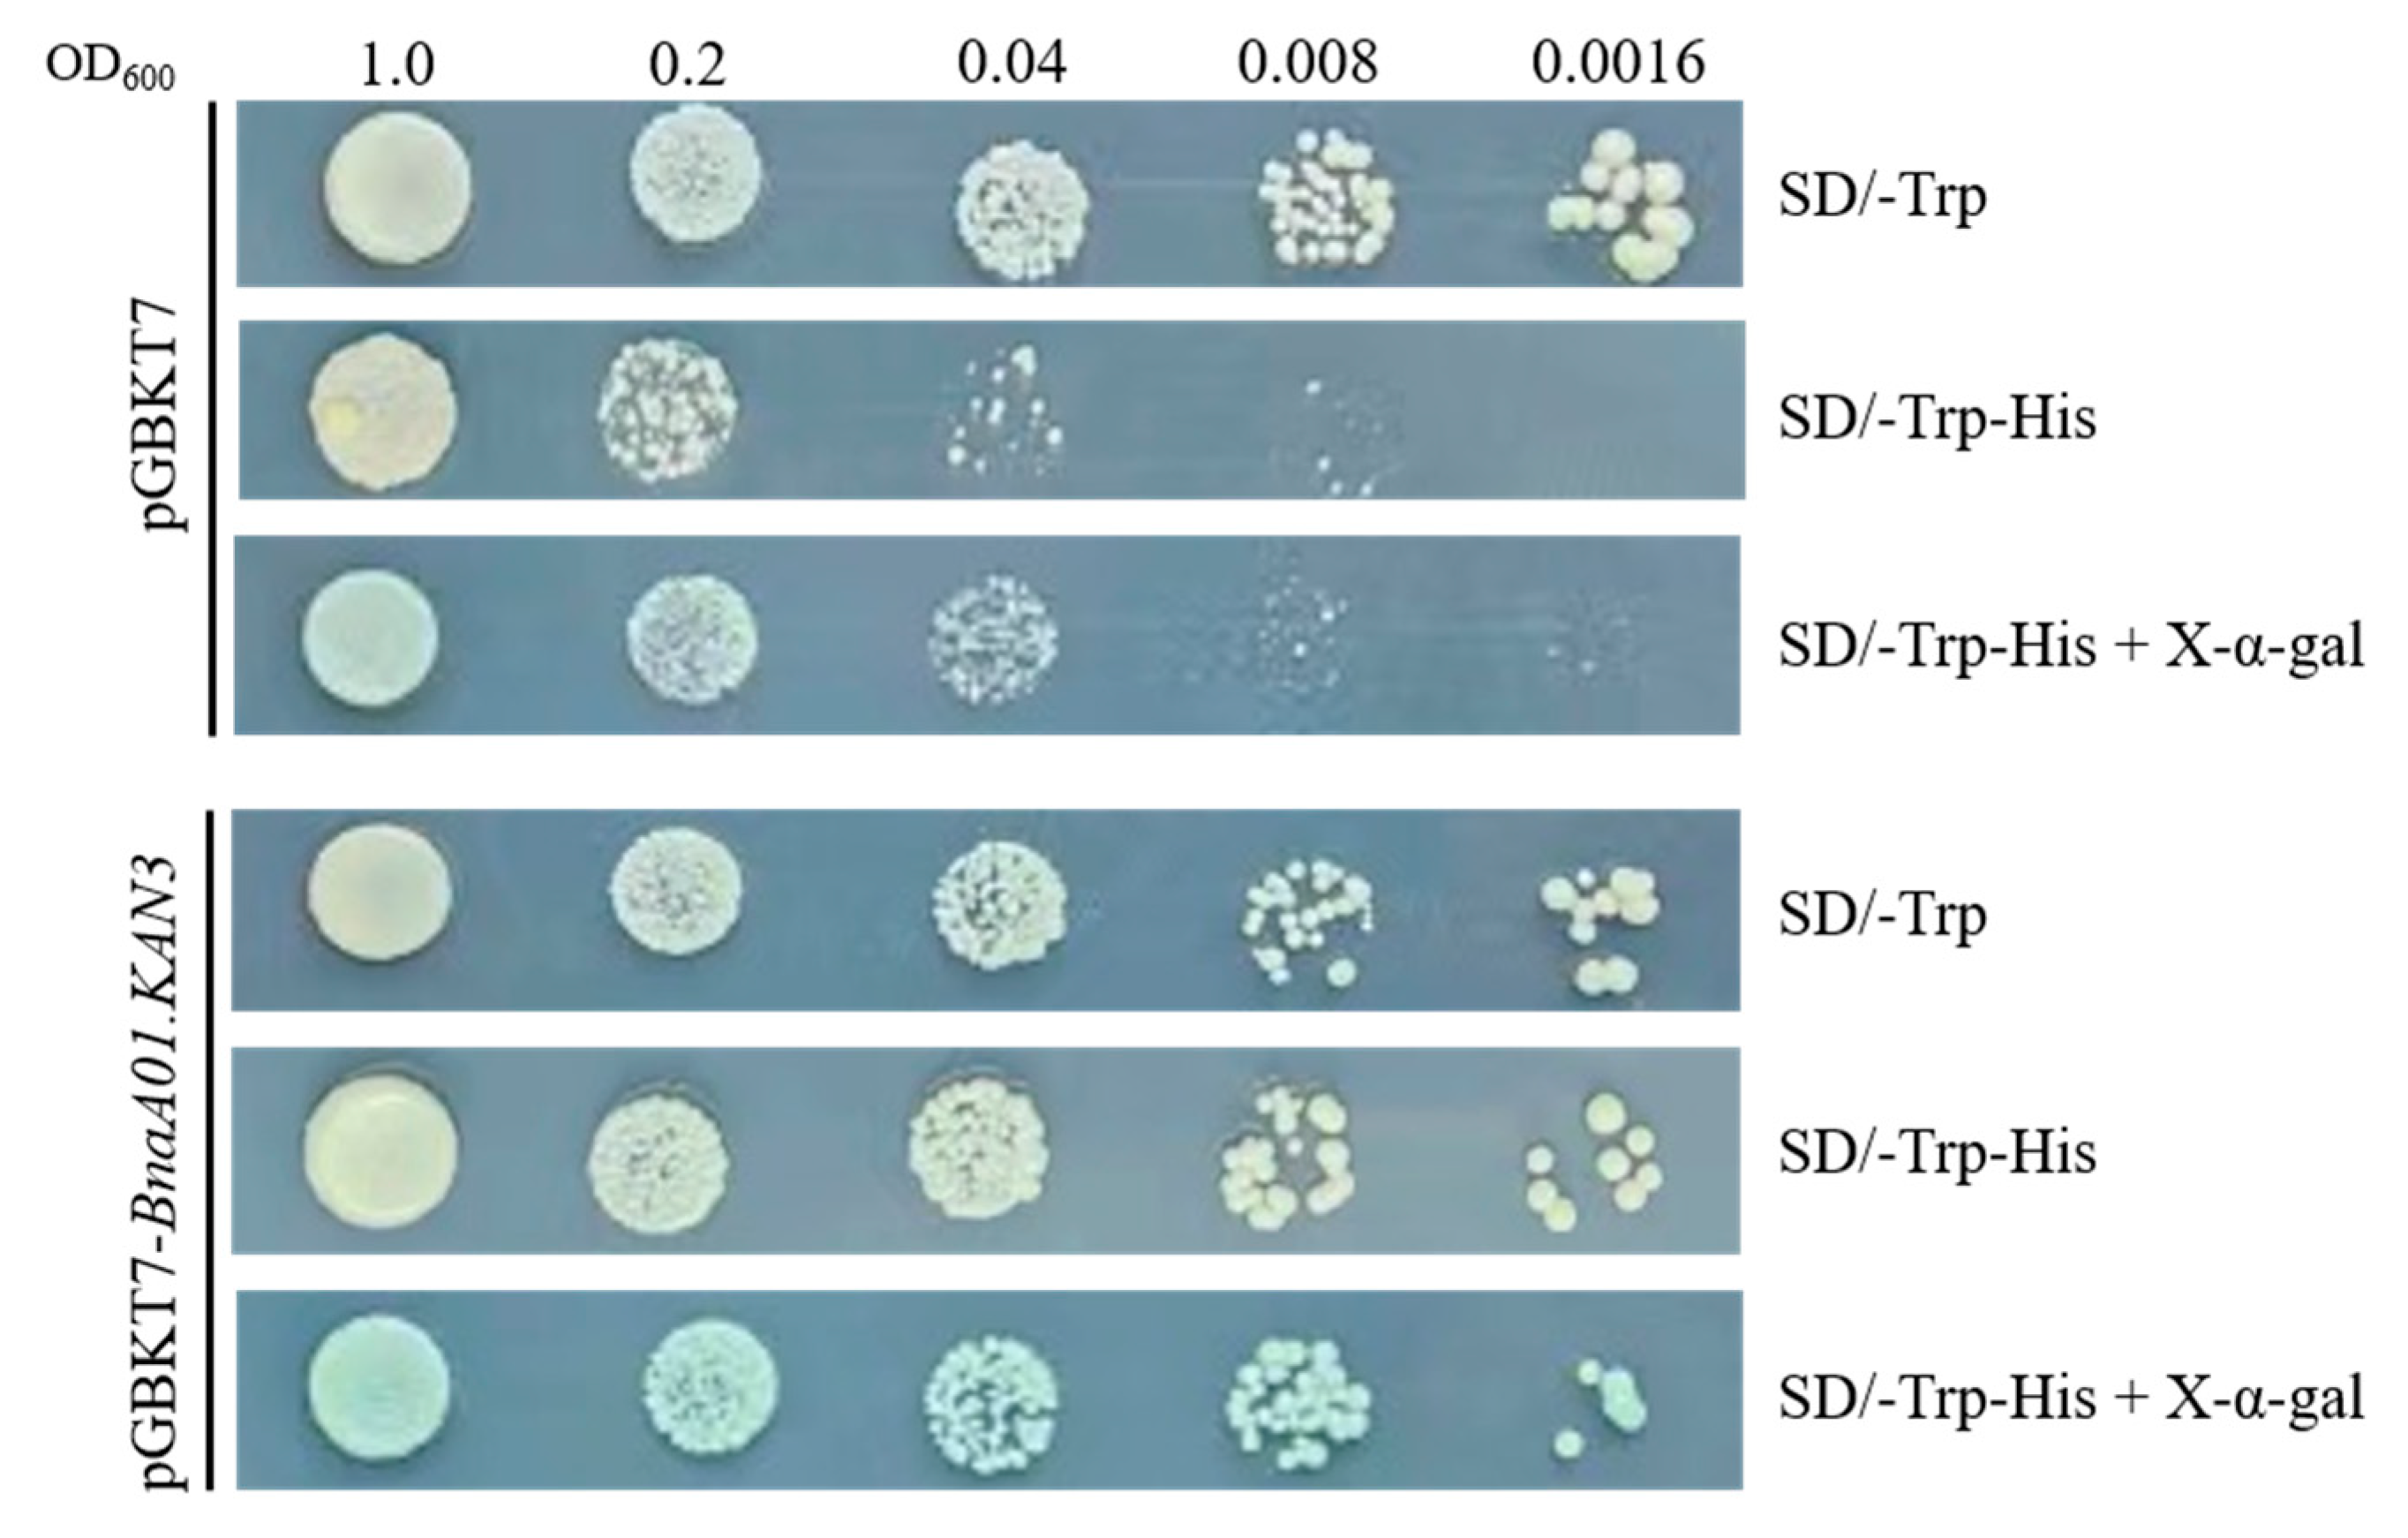
Plants 14 02036 g004

The Novel Transcription Factor BnaA01.KAN3 Is Involved in the Regulation of Anthocyanin Accumulation Under Phosphorus Starvation
Abstract
1. Introduction
2. Results
2.1. Transcription Factor BnaA01.KAN3 Binds to Cis-Element P1BS
2.2. Homology and Phylogenetic Tree Analysis
2.3. Tissue-Specific Expression Pattern and Response to Phosphorus Starvation
2.4. Transcription Auto-Activation of pGBKT7-BnaA01.KAN3
2.5. Subcellular Localization of Fusion Protein BnaA01.KAN3-GFP
2.6. Constructed Transformants with BnaA01.KAN3 Overexpression in A. thaliana
2.7. Phenotype Analysis
2.8. Anthocyanin and Inorganic Phosphorus Measurement
3. Discussion
4. Materials and Methods
4.1. Plant Materials
4.2. Yeast One-Hybrid Assay and EMSA
4.3. Bioinformatics Analysis
4.4. RT-qPCR
4.5. Transcription Auto-Activation Analysis
4.6. Subcellular Localization Analysis
4.7. Plant Transformation and Confirmation
4.8. Phenotype and Physiological Indicator Analysis with Low-Phosphorus Treatment
5. Conclusions
Supplementary Materials
Author Contributions
Funding
Data Availability Statement
Conflicts of Interest
References
- Margalef, O.; Sardans, J.; Fernández-Martínez, M.; Molowny-Horas, R.; Janssens, I.A.; Ciais, P.; Goll, D.; Richter, A.; Obersteiner, M.; Asensio, D.; et al. Global patterns of phosphatase activity in natural soils. Sci. Rep. 2017, 7, 1337. [Google Scholar] [CrossRef]
- Nussaume, L.; Kanno, S.; Javot, H.; Marin, E.; Pochon, N.; Ayadi, A.; Nakanishi, T.M.; Thibaud, M.C. Phosphate import in plants: Focus on the PHT1 transporters. Front. Plant Sci. 2011, 2, 12. [Google Scholar] [CrossRef]
- Yang, S.-Y.; Huang, T.-K.; Kuo, H.-F.; Chiou, T.-J. Role of vacuoles in phosphorus storage and remobilization. J. Exp. Bot. 2017, 68, 3045–3055. [Google Scholar] [CrossRef] [PubMed]
- Sobkowiak, L.; Bielewicz, D.; Malecka, E.M.; Jakobsen, I.; Albrechtsen, M.; Szweykowska-Kulinska, Z.; Pacak, A. The role of the P1BS element containing promoter-driven genes in Pi transport and homeostasis in plants. Front. Plant Sci. 2012, 3, 20102. [Google Scholar] [CrossRef] [PubMed]
- Xiao, J.; Zhou, Y.; Xie, Y.; Li, T.; Su, X.; He, J.; Jiang, Y.; Zhu, H.; Qu, H. ATP homeostasis and signaling in plants. Plant Commun. 2024, 5, 100834. [Google Scholar] [CrossRef] [PubMed]
- Nakamura, Y. Phosphate starvation and membrane lipid remodeling in seed plants. Prog. Lipid Res. 2013, 52, 43–50. [Google Scholar] [CrossRef]
- Lambers, H. Phosphorus acquisition and utilization in plants. Annu. Rev. Plant Biol. 2022, 73, 17–42. [Google Scholar] [CrossRef]
- Bates, T.R.; Lynch, J.P. Stimulation of root hair elongation in Arabidopsis thaliana by low phosphorus availability. Plant Cell Environ. 1996, 19, 529–538. [Google Scholar] [CrossRef]
- Rubio, V.; Linhares, F.; Solano, R.; Martín, A.C.; Iglesias, J.; Leyva, A.; Paz-Ares, J. A conserved MYB transcription factor involved in phosphate starvation signaling both in vascular plants and in unicellular algae. Genes Dev. 2001, 15, 2122–2133. [Google Scholar] [CrossRef]
- Eshed, Y.; Baum, S.F.; Perea, J.V.; Bowman, J.L. Establishment of polarity in lateral organs of plants. Curr. Biol. 2001, 11, 1251–1260. [Google Scholar] [CrossRef]
- Eshed, Y.; Izhaki, A.; Baum, S.F.; Floyd, S.K.; Bowman, J.L. Asymmetric leaf development and blade expansion in Arabidopsis are mediated by KANADI and YABBY activities. Development 2004, 131, 2997–3006. [Google Scholar] [CrossRef] [PubMed]
- Shen, Y.; Chen, J.; Liu, H.; Zhu, W.; Chen, Z.; Zhang, L.; Du, R.; Wu, Z.; Liu, S.; Zhou, S.; et al. Genome-wide identification and analysis of phosphate utilization related genes (PURs) reveal their roles involved in low phosphate responses in Brassica napus L. BMC Plant Biol. 2025, 25, 326. [Google Scholar] [CrossRef]
- Zhao, Z.; Wang, Y.; Shi, J.; Wang, S.; White, P.J.; Shi, L.; Xu, F. Effect of balanced application of boron and phosphorus fertilizers on soil bacterial community, seed yield and phosphorus use efficiency of Brassica napus. Sci. Total. Environ. 2021, 751, 141644. [Google Scholar] [CrossRef] [PubMed]
- Zhao, Z.; Wang, S.; White, P.J.; Wang, Y.; Shi, L.; Xu, F. Boron and phosphorus act synergistically to modulate absorption and distribution of phosphorus and growth of Brassica napus. J. Agric. Food Chem. 2020, 68, 7830–7838. [Google Scholar] [CrossRef]
- Yuan, P.; Ding, G.-D.; Cai, H.-M.; Jin, K.-M.; Broadley, M.R.; Xu, F.-S.; Shi, L. A novel Brassica–rhizotron system to unravel the dynamic changes in root system architecture of oilseed rape under phosphorus deficiency. Ann. Bot. 2016, 118, 173–184. [Google Scholar] [CrossRef]
- Gaude, N.; Nakamura, Y.; Scheible, W.R.; Ohta, H.; Dörmann, P. Phospholipase C5 (NPC5) is involved in galactolipid accumulation during phosphate limitation in leaves of Arabidopsis. Plant J. 2008, 56, 28–39. [Google Scholar] [CrossRef] [PubMed]
- Sega, P.; Pacak, A. Plant PHR transcription factors: Put on a map. Genes 2019, 10, 1018. [Google Scholar] [CrossRef]
- Schünmann, P.H.D.; Richardson, A.E.; Smith, F.W.; Delhaize, E. Characterization of promoter expression patterns derived from the Pht1 phosphate transporter genes of barley (Hordeum vulgare L.). J. Exp. Bot. 2004, 55, 855–865. [Google Scholar] [CrossRef]
- Schünmann, P.H.; Richardson, A.E.; Vickers, C.E.; Delhaize, E. Promoter analysis of the barley Pht1;1 phosphate transporter gene identifies regions controlling root expression and responsiveness to phosphate deprivation. Plant Physiol. 2004, 136, 4205–4214. [Google Scholar] [CrossRef]
- Matthus, E.; Doddrell, N.H.; Guillaume, G.; Mohammad-Sidik, A.B.; Wilkins, K.A.; Swarbreck, S.M.; Davies, J.M. Phosphate deprivation can impair mechano-stimulated cytosolic free calcium elevation in Arabidopsis roots. Plants 2020, 9, 1205. [Google Scholar] [CrossRef]
- Ngo, A.H.; Nakamura, Y.; Takahashi, H. Phosphate starvation-inducible GLYCEROPHOSPHODIESTER PHOSPHODIESTERASE6 is involved in Arabidopsis root growth. J. Exp. Bot. 2022, 73, 2995–3003. [Google Scholar] [CrossRef] [PubMed]
- Vance, C.P.; Uhde-Stone, C.; Allan, D.L. Phosphorus acquisition and use: Critical adaptations by plants for securing a nonrenewable resource. New Phytol. 2003, 157, 423–447. [Google Scholar] [CrossRef] [PubMed]
- Nilsson, L.; Müller, R.; Nielsen, T.H. Dissecting the plant transcriptome and the regulatory responses to phosphate deprivation. Physiol. Plant. 2010, 139, 129–143. [Google Scholar] [CrossRef] [PubMed]
- Plaxton, W.C.; Tran, H.T. Metabolic adaptations of phosphate-starved plants. Plant Physiol. 2011, 156, 1006–1015. [Google Scholar] [CrossRef]
- Livak, K.J.; Schmittgen, T.D. Analysis of relative gene expression data using real-time quantitative PCR and the 2(-Delta Delta C(T)) Method. Methods 2001, 25, 402–408. [Google Scholar] [CrossRef]

Disclaimer/Publisher’s Note: The statements, opinions and data contained in all publications are solely those of the individual author(s) and contributor(s) and not of MDPI and/or the editor(s). MDPI and/or the editor(s) disclaim responsibility for any injury to people or property resulting from any ideas, methods, instructions or products referred to in the content. |
© 2025 by the authors. Licensee MDPI, Basel, Switzerland. This article is an open access article distributed under the terms and conditions of the Creative Commons Attribution (CC BY) license (https://creativecommons.org/licenses/by/4.0/).
Share and Cite
He, L.; Peng, S.; Lin, R.; Zhang, J.; Cui, P.; Gan, Y.; Liu, H. The Novel Transcription Factor BnaA01.KAN3 Is Involved in the Regulation of Anthocyanin Accumulation Under Phosphorus Starvation. Plants 2025, 14, 2036. https://doi.org/10.3390/plants14132036
He L, Peng S, Lin R, Zhang J, Cui P, Gan Y, Liu H. The Novel Transcription Factor BnaA01.KAN3 Is Involved in the Regulation of Anthocyanin Accumulation Under Phosphorus Starvation. Plants. 2025; 14(13):2036. https://doi.org/10.3390/plants14132036
Chicago/Turabian StyleHe, Li, Shan Peng, Ruihua Lin, Jiahui Zhang, Peng Cui, Yi Gan, and Hongbo Liu. 2025. "The Novel Transcription Factor BnaA01.KAN3 Is Involved in the Regulation of Anthocyanin Accumulation Under Phosphorus Starvation" Plants 14, no. 13: 2036. https://doi.org/10.3390/plants14132036
APA StyleHe, L., Peng, S., Lin, R., Zhang, J., Cui, P., Gan, Y., & Liu, H. (2025). The Novel Transcription Factor BnaA01.KAN3 Is Involved in the Regulation of Anthocyanin Accumulation Under Phosphorus Starvation. Plants, 14(13), 2036. https://doi.org/10.3390/plants14132036

